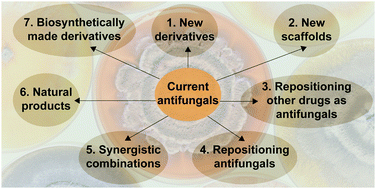

Safe Antifungal In Liver Disease
Safe antifungal in liver disease. However avoid it if you do have liver problems. Unlike Plavix these medications may not be safe with Aspirin and other over the counter pain relievers. For anyone with liver disease taking in oral anti-fungal.
Antibiotics to be avoided in liver disease. Pre-existing liver disease in patients with IFIs raises significant concern about the safety of antifungal agent administration. A number of antifungals require biotransformation into more water-soluble metabolites by the liver before excretion from the body.
These anti-fungal drugs are available on prescription from your doctor. Fortunately the effects of impaired kidney and liver function on antifungal. The liver filters almost 15 liters of blood every minute cleansing the body of bacteria viruses fungi and toxins and helping to fight disease.
Antifungal drugs like Ketocanozole and miconazole though hepatotoxic can be used in patients with cirrhosis but monitor drug concentration in serum is recommended. Antifungal Dosage Adjustment in Hepatic Failure. While using these treatments tackle any oral infections by gargling with tea tree oil 1 in 10 dilution every night.
Some of the enzymes in the liver are called the cytochrome P450 enzymes. Vaccination of adults with chronic liver disease of viral or nonviral etiology produced seroprotection rates similar to those observed in healthy adults22 However seroconversion rates are. Some people just dont respond to Plavix clopidogrel.
Terbinafine an allylamine is fungicidal and remains at therapeutic levels in keratinized tissues but with a. Antifungal related liver injury typically manifests as elevations in serum aminotransferase. Risk of developing antifungal associated hepatotoxicity is multifactorial and is influenced by pre-existing liver disease chemical properties of the drug patient demographics comorbidities drug-drug interactions environmental and genetic factors.
Considerations for Oral Medications. This article focuses on the acute and chronic treatment of seizur.
The liver is the primary site of drug metabolism and hepatic disease can significantly alter the PKs of antifungal drugs mainly through impaired clearance 4.
Some people just dont respond to Plavix clopidogrel. Fortunately the effects of impaired kidney and liver function on antifungal. 30 Prompt OLT accompanied by adequate antifungal therapy may be. Acute symptomatic seizures or epilepsy may complicate the course of hepatic disease. A number of antifungals require biotransformation into more water-soluble metabolites by the liver before excretion from the body. These enzymes act on all sorts of toxins metabolic by-products and drugs to reduce their toxicity and function to allow these detoxified substances to be safely excreted. There is a general apprehension that exists regarding acetaminophen use in patients with advanced liver disease given the association between acetaminophen overdose and acute liver failure. However avoid it if you do have liver problems. Safe and Effective Treatment For Nail Fungal Infections Topical Treatments.
Certain antifungal drugs such as ketocanozole and certain antibiotics such as rifampin interfere with the action of liver enzymes needed to keep the medications active. Unlike Plavix these medications may not be safe with Aspirin and other over the counter pain relievers. Safe and Effective Treatment For Nail Fungal Infections Topical Treatments. Acute symptomatic seizures or epilepsy may complicate the course of hepatic disease. Metronidazole reduce dose by 50 in patients with severe cirrhosis andor associated renal insufficiency. Considerations for Oral Medications. Certain antifungal drugs such as ketocanozole and certain antibiotics such as rifampin interfere with the action of liver enzymes needed to keep the medications active.

Post a Comment for "Safe Antifungal In Liver Disease"